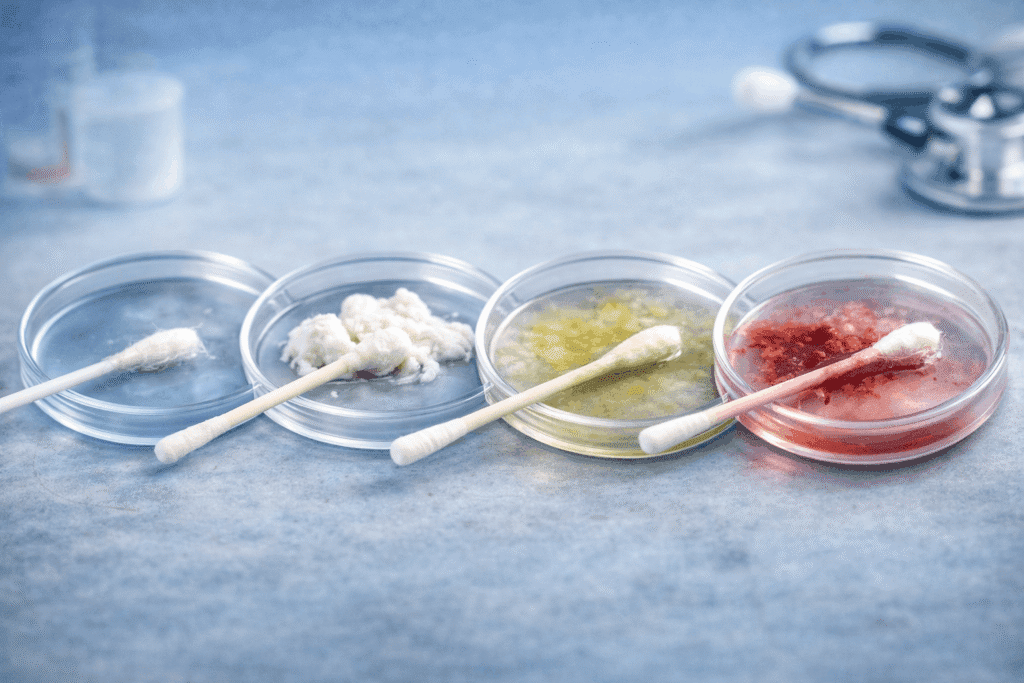
Comparison image showing different vaginal discharge patterns including clear watery, thick white clumpy, yellow-green, and blood-stained discharge

Written by: Abiola Johnson
Reviewed by: Dr. Joan Chika
Medically reviewed: March 25, 2026
Vaginal discharge is normal in many cases. It is one of the ways the vagina keeps itself clean, moist, and protected. Healthy discharge is usually clear or white and does not have a strong unpleasant smell. It can also change slightly during the menstrual cycle, around ovulation, in pregnancy, and with sexual arousal. As ACOG explains, discharge becomes more concerning when it changes in color, smell, amount, or texture, or starts coming with symptoms like itching, burning, sores, pelvic pain, or bleeding.
Quick answer
Vaginal discharge is usually normal when it is clear or white, mild-smelling or odorless, and not causing irritation. It may be abnormal if it becomes fishy-smelling, thick and clumpy, green, yellow, frothy, blood-stained, or suddenly unusual for you, especially when it comes with itching, burning, pain when urinating, pelvic pain, bleeding between periods, or pain during sex. Both ACOG and the NHS guide to vaginal discharge describe this pattern clearly.
What normal vaginal discharge looks like
Normal discharge is not a sign that something is wrong. It often looks clear, milky, or white. Some women notice more of it at certain times of the month, especially near ovulation. Pregnancy and sexual arousal can also increase it. On its own, that does not mean infection, as noted by both ACOG and MedlinePlus.
That is why not every discharge should be called “toilet infection.” Many women worry when they notice discharge, but normal vaginal discharge is part of healthy vaginal function. The more useful question is whether it has changed in a clearly abnormal way for you.
When vaginal discharge is abnormal
Discharge is more likely to be abnormal when it changes in smell, color, texture, or amount, especially if it comes with other symptoms. Red flags include:
- a strong fishy or foul smell
- thick white clumps with itching or burning
- green, yellow, or frothy discharge
- blood-stained discharge unrelated to your period
- discharge with pelvic pain, sores, pain during sex, or pain when urinating
- discharge with bleeding between periods or after sex
The NHS makes it clear that these changes can point to infection or another problem, while the CDC’s vaginal discharge guidance also notes that symptoms often overlap, which is one reason self-diagnosis frequently goes wrong.
Normal vs abnormal vaginal discharge
Here is a simple way to think about it.
More likely to be normal
- clear, white, or milky
- no strong unpleasant odor
- mild day-to-day variation
- more noticeable around ovulation, pregnancy, or arousal
- no itching, burning, pain, sores, or bleeding
More likely to be abnormal
- fishy-smelling
- thick, curdy, or clumpy
- green, yellow, grey, or frothy
- mixed with blood outside your normal period
- paired with itching, soreness, burning, pelvic pain, fever, or painful urination
This normal-versus-abnormal pattern matches the symptom guidance given by ACOG and the NHS.
Common causes of abnormal vaginal discharge
Bacterial vaginosis
Bacterial vaginosis, or BV, is one of the most common causes of unusual discharge. It often causes a thin discharge with a fishy smell. The CDC’s BV treatment guideline describes BV as commonly presenting with a homogeneous thin discharge, while NHS guidance on bacterial vaginosis highlights the characteristic fishy odor.
Vaginal yeast infection
A yeast infection often causes thick white discharge, sometimes described as curdy or cottage-cheese-like, along with itching, burning, redness, and irritation. The CDC guidance on vulvovaginal candidiasis and MedlinePlus information on yeast infection both describe this classic pattern. For a fuller breakdown, see our guide to vaginal yeast infection symptoms, causes, and treatment.
Trichomoniasis
Trichomoniasis is an STI that can cause yellow-green or frothy discharge, odor, irritation, and pain when urinating. The NHS page on trichomoniasis notes that symptoms can vary, and some people have no symptoms at all.
Chlamydia or gonorrhea
Some STIs can cause discharge, burning during urination, bleeding between periods, or pelvic discomfort, but many women have mild symptoms or none at all. That makes them easy to miss or mistake for something less serious. For a clearer comparison of overlapping symptoms, read our guide to yeast infection vs BV vs STI. The CDC’s gonorrhea overview also notes that some infections may cause only subtle symptoms.
Irritation from products or habits
Not every abnormal discharge is caused by infection. ACOG’s vulvovaginal health guidance advises avoiding perfumed products on the inner vulva, while MedlinePlus notes that douching, sprays, creams, dyes, and other irritating products can make symptoms worse.
Medication-related changes
Antibiotics can sometimes disrupt the normal balance of vaginal organisms and increase the risk of candidiasis. This can matter when unusual discharge starts soon after a course of medication. If that sounds familiar, read our article on common drugs that affect your vagina. The connection between antibiotics and yeast overgrowth is also recognized in the CDC candidiasis guideline.
What different discharge patterns can suggest
Clear or white
This is usually normal, especially when there is no strong odor, itching, burning, or pain. ACOG notes that this kind of discharge can also increase during ovulation, pregnancy, or arousal.
Thick white and clumpy
This often points toward a yeast infection, especially when there is itching or burning, as described in the NHS guide to vaginal discharge.
Thin grey or off-white with fishy smell
This often suggests bacterial vaginosis, which is how both the NHS and the CDC commonly describe it.
Yellow, green, or frothy
This may suggest trichomoniasis or another infection, based on symptom descriptions from the NHS and the CDC.
Blood-stained or mixed with unusual bleeding
This needs proper assessment, especially if it happens between periods, after sex, or during pregnancy. The NHS treats bleeding with discharge as something that should not be ignored.
Common self-diagnosis mistakes
One of the biggest mistakes is assuming that every discharge is an infection. Another is assuming that color alone tells you the cause. Thick white discharge may suggest yeast infection, but symptoms overlap. Fishy odor may suggest BV, but it is not the only possibility. STI-related discharge can also be mild, vague, or mistaken for something else, which is why the CDC’s vaginal discharge guideline warns that symptoms and history alone are often not enough for diagnosis.
Another mistake is treating yourself too quickly without knowing what you are treating. Guessing wrong can delay the right treatment and keep symptoms dragging on longer than they should.
When to see a doctor

See a doctor or qualified clinician if your discharge:
- smells clearly unpleasant or fishy
- turns green, yellow, grey, frothy, or blood-stained
- is thick and white with strong itching or burning
- comes with pelvic pain, fever, painful urination, sores, or pain during sex
- comes with bleeding between periods or after sex
- keeps coming back
- appears abnormal during pregnancy
These warning signs are consistent with the advice in the NHS symptom guide.
Red flags you should not ignore
Seek urgent medical attention if abnormal discharge comes with severe pelvic pain, fever, vomiting, feeling very unwell, or unusual bleeding, especially if pregnancy is possible. The CDC’s information on PID explains why symptoms like lower abdominal pain, fever, bad-smelling discharge, and bleeding deserve prompt evaluation.
The bottom line
Vaginal discharge is often normal. The real issue is whether it has become clearly abnormal for you. Clear or white discharge without a strong smell is often part of healthy vaginal function. Discharge deserves more attention when it becomes fishy, green, yellow, frothy, thick and clumpy, blood-stained, or starts coming with itching, burning, pain, sores, or bleeding. In those cases, it is smarter to get properly assessed than to guess.
FAQs
Is vaginal discharge normal every day?
It can be. Normal discharge varies from person to person and can change during the cycle. As ACOG notes, clear or white discharge without a strong unpleasant odor is often normal.
Does abnormal discharge always mean an STI?
No. It may be caused by BV, yeast infection, irritation, trichomoniasis, chlamydia, gonorrhea, or other conditions, as outlined in the NHS overview of vaginal discharge.
Can antibiotics cause discharge changes?
They can. Antibiotics can increase the risk of candidiasis in some people, which may then lead to itching and abnormal discharge, as explained in the CDC candidiasis guideline.
Should I self-treat if I think it is yeast infection?
Not always. Different causes of discharge can look similar, and the CDC’s guidance on vaginal discharge notes that symptoms and history alone are often not enough to diagnose vaginitis accurately.
Medical Disclaimer: This article is for educational and informational purposes only and is not a substitute for professional medical advice, diagnosis, or treatment. Always speak with a qualified healthcare professional about personal health concerns.




